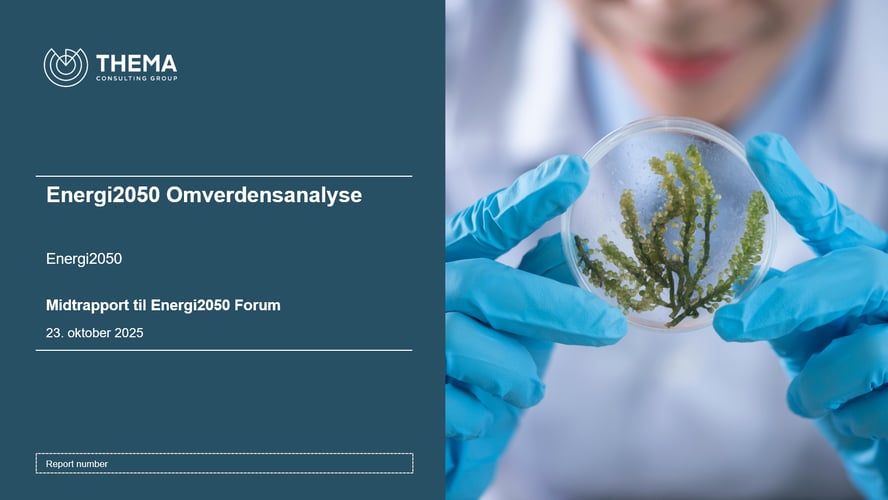

Energi2050 ønsker innspill til omverdensanalysen
Energi2050 ønsker innspill til omverdensanalysen.
Energi2050 utarbeider en omverdensanalyse i samarbeid med THEMA.
Utkastet ble presentert på Energi2050-forum, 23.oktober 2025.
Utkastet kan nå lastes ned via denne lenken.
Eventuelle kommentarer sendes inn via dette innspillsskjemaet. Tidsfrist for innspill er 13.november 2025.
Meldinger ved utskriftstidspunkt 29. januar 2026, kl. 02.10 CET
Det ble ikke vist noen globale meldinger eller andre viktige meldinger da dette dokumentet ble skrevet ut.